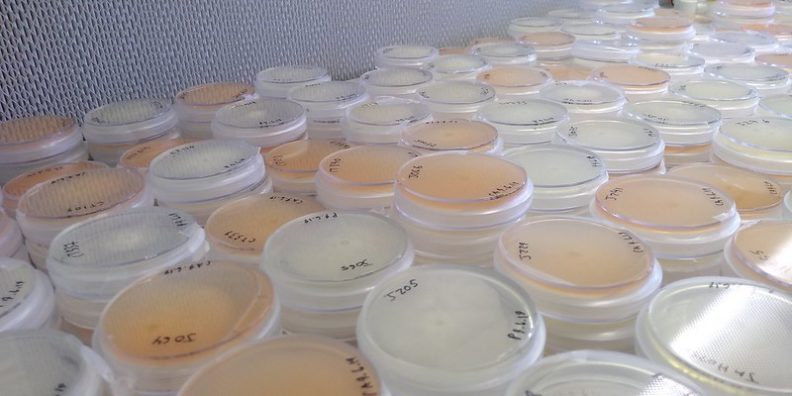
Phytophthora is cultured on petri dishes filled with nutrient agar.

Sudden Oak Death Education


WSU Puyallup developed a program to provide educational material and activities relating to P. ramorum and other Phytophthora diseases throughout Washington with funding originally provided by the USDA Forest Service and National Plant Diagnostic Network, and by WSDA.
Below we provide educational resources for homeowners, land managers, Master Gardeners, and nursery professionals. These resources include guides for symptom recognition, early detection and management of Phytophthora diseases such as SOD. Early detection is key for protecting Washington’s nursery, landscape, and forest industries from the effects of P. ramorum and other invasive plant diseases.
Developing Best Management Practices (BMPs) for nurseries is an important component of the WSU SOD Education Program. Proper use of BMPs will help nurseries prevent or mitigate infestations by P. ramorum and other invasive plant diseases.
The WSU Puyallup program also provides opportunities for local students to obtain research experience by working with us on various projects related to Phytophthora.
General Information
Sudden Oak Death
- USDA National Invasive Species Information Center
- USDA-APHIS P. ramorum website
- California Oak Mortality Task Force (COMTF) website – Complete, up to date information about SOD — mostly relevant to California, but includes links to other areas
- P. ramorum present in the UK – Get the latest news on the P. ramorum situation in the UK, where the disease has spread to larch and other conifers.
Hosts and identification
- WSU Symptom ID Guide
- Symptoms on various hosts (OSU & WSU) (pdf)
- P. ramorum host list from USDA-APHIS (pdf)
Phytophthora diseases
Diagnostics – Do I have Phytophthora ramorum?

Information for Specific Audiences
Click on the images below to find the information most relevant to you.
Información en español
More Information and Resources
External Resources
WSU Publications
Brochures
WSU Puyallup Research & Extension Center
2606 West Pioneer, Puyallup, WA, 98371-4998 USA
Last updated 9/25/2025





















